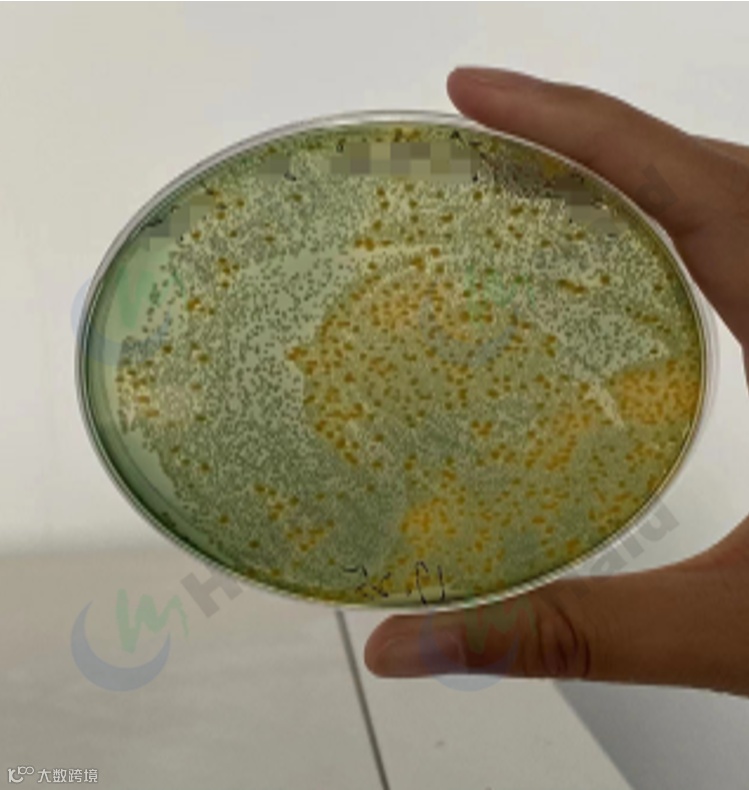

文 | 图 浙江海大 胡枭偲
扫浑期作为小棚养殖的重要节点之一,需从投喂、肥水、补菌、改底等几方面同时操作,才能达到预期的效果。
浑水期作为小棚养殖的重要节点之一,氮循环及弧菌问题需要引起重视!其中,氨氮转亚盐是否顺利决定着扫浑期加料是否顺畅,投喂曲线整体是否平顺。
长时间的高氨氮水质导致扫浑期加料不顺,长时间慢料,影响养殖户的正常投喂,拖延养殖节奏,且过高的氨氮也会影响虾子的健康,导致肠炎、偷死等现象。
那怎样才能降低氨氮顶峰值,减少氨氮转亚盐的时间?扫浑期又需要如何管理呢?
跟着本篇文章咱们一起来看看吧!
为了了解在本土化模式养殖下的小棚养殖,海大技术团队专门对2022年的部分养户进行了调研,探究氮循环的变化规律,总结氨氮对养殖过程及最终产量的影响。

△2022年养殖数据跟踪
从数据可看出,这3名养户有一个共同的特点:氨氮峰值高(4.5-7),氨氮转亚盐时间长(>14天),即氨氮在该阶段长时间处于较高水平,存在慢料、偷死掉苗、黄鳃等隐患,进而影响最终产量。

△2022年园区产量数据
从上表可看出,扫浑期氨氮的峰值及转换的时间会直接影响最后虾的产量,以上3位养户的产量要低于整体的平均产量,因此扫浑期氨氮的问题一定要重视!
浑水期氮循环不畅,相应水质也会发生变化。下面来给大家解释一下原因,知己知彼我们才能对症下药。
当养殖进入(20-25)天,累计投喂(100-110)斤时,虾子长到一定规格,爬底能力加强,搅起水底泥沙,从而形成扫浑。
1.藻类丰度波动大,氨氮弧菌齐发威
在这个阶段,水体藻相开始发生转变,由于扫浑后水体浊度上升,透光性变差,生活在中下层的喜光藻类丰度快速下降;作为氨氮吸收的主要途径,藻类丰度的下降,加之投喂量的加大,氨氮则会快速累积,弧菌作为条件致病菌,也易滋生。
我们对小棚总菌和弧菌的变化规律做了跟踪,发现弧菌数量增加是对虾肠炎慢料的内因之一。

△藻类波动大,丰度降低
△扫浑期弧菌爆表
2.溶氧下降底变差,投喂超量虾偷死
藻类丰度与结构的变化,会造成溶氧的波动以及氨氮的累积,使虾子处于一个长期胁迫的状态,这个时候随着投喂量的增加,水中的有机质积累,造成塘底变差,塘底氧债也会随之增加,这必然导致整个水体溶氧的下降,进而出现浮头、跳塘甚至爆塘情况。

△扫浑期溶氧呈现下降趋势,不予控制溶氧甚至会低于3ppm
摸清原因,即可对症下药!思路很简单,注意下面这几个关键点,安全渡过浑水期。
1.饲料档次升级,提升饲料利用率
通过近两年养殖数据的对比,不管是从水质管理、长势、虾健康状况还是养殖效益来看,功能料的优势都较为明显。

海大虾多康,采用优质的原料、蛋白质含量高、适口性以及对虾的摄食效率远高于其他普通饲料,其中特添加中草药成分,能够增强虾子的免疫力,让对虾平稳渡过浑水期。

△相较于普通料,虾多康使用过程氨氮波动幅度更小,峰值更低,摄食效率远优于普通料
2.扫浑稳投喂,减少料浪费
进入扫浑期,水环境较之浑水前会发生巨大变化,氨氮累积是必然,为了防止氨氮进一步升高,需要控制氮的来源,即稳投喂、控料。

△不同投喂方式造成的氨氮差异
从以上数据来看,在养殖第17天,转完03料阶段开始,部分养户开始加料,与保守养户相比,截止到第24天,单棚累计投喂量差异达到10斤,差异占累积投喂的1/10;数据表明,过量投喂会造成氨氮提前升高,较常规投喂高0.7ppm,因而此时冲料过猛,会对后面养殖带来负面影响,建议控料、稳投喂。
3.肥水黑科技,增加氮去路
小棚模式中,氨氮吸收的任务主要被藻类及菌类承担,肥水补菌显得尤为重要。
众所周知,藻类生长的必须元素为氮、磷、钾。浑水期水体氨氮累积,池塘中氮元素充沛,这个时候盲目使用氮肥进行肥水,无疑会加重水体的氨氮水平。
经过长时间的走访及产品验证,海大推出了养水精华产品。作为“无氮肥”,“养水精华”选用多种类型的优质原料,包含藻类提取物、藻类生长的微量元素、生长因子、营养盐等,能高效补充水体藻类生长需要的微量元素,促进藻类生长,进而吸收水中多余的氨氮,配合海大菌藻旺及钙镁佳等产品使用,肥水效果更佳。
以40张棚为例,菌藻旺2包+养水精华4包+钙镁佳 1包

汀罗海联科肥水方案效果:使用后氨氮在5-7天即转换为亚盐。

4.消毒增氧勤改底,虾子无忧过浑水
浑水期水质波动大,底部有机质堆积,极易造成底部的氧债累积,弧菌滋生,经过对海大养殖基地的跟踪,我们建议养殖户在浑水期提早进行消毒、改底,并增加水体溶氧。


△方案部分执行养户水质

△方案完全执行养户水质
浙江海大技术团队通过跟踪发现,严格执行我司方案的客户,溶氧始终保持在5.5-6ppm之间,在扫浑期间氨氮峰值更低(<1.2ppm),上升曲线更平缓,对弧菌的防控效果也越好,弧菌数量始终低于200cfu/mL。
扫浑期作为小棚养殖的重要节点之一,需从投喂、肥水、补菌、改底等几方面同时操作,才能达到预期的效果。
作为最早进入山东小棚养殖业的团队,浙江海大服务团队这两年多里一直扎根养殖一线,深挖养殖技术关键点,从养殖前操作、放苗密度及出虾时间都有成体系的流程。世上无难事,只怕有心人,相信在大家的配合下,虽经历险阻,“氮”定能达成所愿!
END
本文系海大农牧(微信号:haid002311)原创,未经授权,一律禁止转载!文章投稿、转载授权,欢迎发邮件到:haidnm@haid.com.cn

